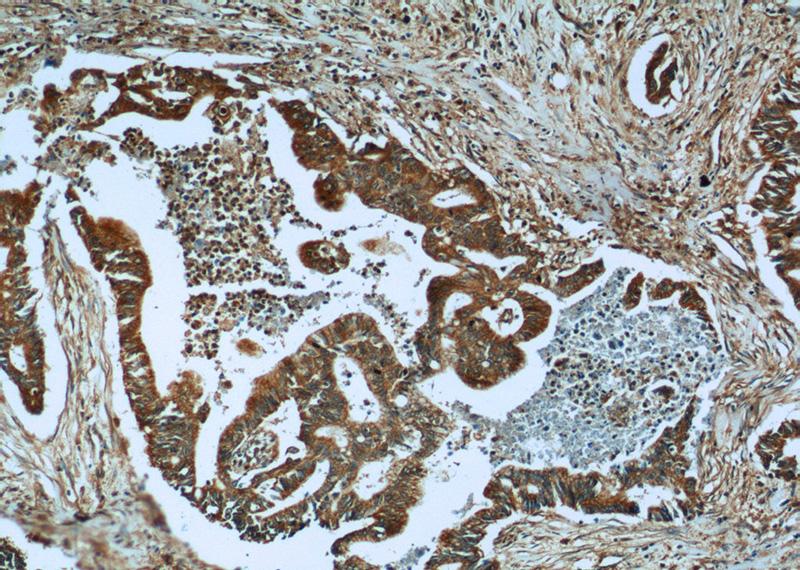
Immunohistochemistry of paraffin-embedded human pancreas cancer tissue slide using Catalog No:116260(PLAT Antibody) at dilution of 1:50 (under 10x lens)

-
Product Name
tPA antibody
- Documents
-
Description
tPA Rabbit Polyclonal antibody. Positive IHC detected in human pancreas cancer tissue, human ovary tumor tissue, human placenta tissue. Positive IP detected in mouse kidney tissue. Positive WB detected in mouse pancreas tissue, mouse kidney tissue. Observed molecular weight by Western-blot: 32-35 kDa, 65 kDa
-
Tested applications
ELISA, WB, IHC, IP
-
Species reactivity
Human,Mouse,Rat; other species not tested.
-
Alternative names
Alteplase antibody; DKFZp686I03148 antibody; plasminogen activator antibody; tissue antibody; PLAT antibody; Reteplase antibody; T PA antibody; t plasminogen activator antibody; Tissue Plasminogen Activator antibody; tPA antibody
-
Isotype
Rabbit IgG
-
Preparation
This antibody was obtained by immunization of tPA recombinant protein (Accession Number: NM_033011). Purification method: Antigen affinity purified.
-
Clonality
Polyclonal
-
Formulation
PBS with 0.1% sodium azide and 50% glycerol pH 7.3.
-
Storage instructions
Store at -20℃. DO NOT ALIQUOT
-
Applications
Recommended Dilution:
WB: 1:500-1:5000
IP: 1:500-1:5000
IHC: 1:20-1:200
-
Validations

mouse pancreas tissue were subjected to SDS PAGE followed by western blot with Catalog No:116260(PLAT antibody) at dilution of 1:1000

IP Result of anti-PLAT (IP:Catalog No:116260, 3ug; Detection:Catalog No:116260 1:1000) with mouse kidney tissue lysate 4000ug.
Immunohistochemistry of paraffin-embedded human pancreas cancer tissue slide using Catalog No:116260(PLAT Antibody) at dilution of 1:50 (under 10x lens)

Immunohistochemistry of paraffin-embedded human pancreas cancer tissue slide using Catalog No:116260(PLAT Antibody) at dilution of 1:50 (under 40x lens)
-
Background
Plasminogen activator, tissue (PLAT, synonyms: TPA, T-PA) is a tissue-type plasminogen activator, a secreted serine protease which converts the proenzyme plasminogen to plasmin, a fibrinolytic enzyme. Tissue-type plasminogen activator is synthesized as a single chain which is cleaved by plasmin to a two chain disulfide linked protein. PLAT enzyme plays a role in cell migration and tissue remodeling. Increased enzymatic activity causes hyperfibrinolysis, which manifests as excessive bleeding; decreased activity leads to hypofibrinolysis which can result in thrombosis or embolism. tPA has 4 isoforms produced by alternative splicing with the MW of 63 kDa, 33 kDa, 57 kDa and 44 kDa.
-
References
- Zhi X, Xu C, Zhang H. Tryptase promotes atherosclerotic plaque haemorrhage in ApoE-/- mice. PloS one. 8(4):e60960. 2013.
- Achuta VS, Rezov V, Uutela M, Louhivuori V, Louhivuori L, Castrén ML. Tissue plasminogen activator contributes to alterations of neuronal migration and activity-dependent responses in fragile X mice. The Journal of neuroscience : the official journal of the Society for Neuroscience. 34(5):1916-23. 2014.
Related Products / Services
Please note: All products are "FOR RESEARCH USE ONLY AND ARE NOT INTENDED FOR DIAGNOSTIC OR THERAPEUTIC USE"
